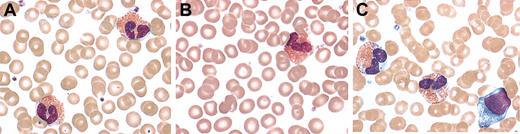
Figure 1. Peripheral blood smears. Representative peripheral blood eosinophils from a patient with FE (A), an NL family member (B), and a patient with HES (C) stained with modified Wright stain (original magnification, × 1000). There is evidence of dysplasia with areas of cytoplasmic clearing only in the eosinophils from the patient with HES.

Abstract
Familial eosinophilia (FE) is an autosomal dominant disorder characterized by marked eosinophilia and progression to end organ damage in some, but not all, affected family members. To better define the pathogenesis of FE, 13 affected and 11 unaffected family members (NLs) underwent a detailed clinical evaluation at the National Institutes of Health (NIH). No clinical abnormalities were more frequent in the family members with FE compared with the NLs. There was, however, a decreased prevalence of asthma in family members with FE compared with unaffected family members. Eosinophil morphology as assessed by either light or transmission electron microscopy was normal in family members with and without FE. Although levels of eosinophil-derived neurotoxin (EDN) and major basic protein (MBP) were elevated in patients with FE compared with NL, levels of both granule proteins were lower than in nonfamilial hypereosinophilic syndrome (HES). Similarly, increased surface expression of the activation markers CD69, CD25, and HLA-DR was detected by flow cytometry on eosinophils from patients with FE compared with NL, albeit less than that seen in HES. These data suggest that, despite prolonged marked eosinophilia, FE can be distinguished from HES by a more benign clinical course that may be related to a relative lack of eosinophil activation.
Introduction
Marked eosinophilia (> 1.5 × 109/L) is a relatively uncommon finding that may be seen in association with drug hypersensitivity, helminth infection, and, less commonly, with neoplasia, rheumatologic disorders, and other conditions associated with immune dysregulation. Hypereosinophilic syndrome (HES) is a heterogeneous group of disorders that has been defined as peripheral eosinophilia of more than 1.5 × 109/L for at least 6 months and evidence of end organ involvement in the absence of an identifiable cause.1,2 Some patients with HES present with severe end organ damage, including endomyocardial fibrosis, restrictive pulmonary disease, and peripheral neuropathy, whereas others remain relatively asymptomatic for decades. The recent identification and clinical characterization of a subgroup of patients with a specific molecular defect3,4 suggests that the underlying etiology of the eosinophilia may play an important role in determining the clinical manifestations of HES. Regardless of the etiology of the eosinophilia, however, the severity of the clinical pathology in HES is felt to reflect the extent of eosinophil activation in the tissues, and eosinophil granule proteins have been demonstrated in the serum and affected tissues of patients with HES.5-7
We have previously described a 5-generation kindred with autosomal dominant transmission of marked eosinophilia (familial eosinophilia [FE]; Mendelian Inheritance in Man [MIM] 131400) in which progression to end organ damage (endomyocardial fibrosis and/or neuropathy) has occurred in a small subset (5 of 19) of affected family members.8 Eosinophilia has been documented as early as 4 months of age and is remarkably stable over time in affected family members. The gene responsible for this condition has been mapped to the cytokine gene cluster on human chromosomal region 5q31-q33 but does not appear to be due to mutations in the genes encoding interleukin 3 (IL-3), IL-4, IL-5, IL-13, granulocyte-macrophage colony-stimulating factor (GM-CSF), the glucocorticoid receptor, their promoters, or within the IL-3/GM-CSF enhancer (Rioux et al9 ; J. Rioux et al, unpublished results, June 2001). In order to better define the pathogenesis of FE, a detailed clinical and immunologic evaluation of 15 affected and 16 unaffected family members was performed.
Patients, materials, and methods
Patient population
All affected members of the previously defined kindred with familial eosinophilia, their siblings, and their children were invited to participate in the study. Of the 51 family members contacted, 31 (15 affected [FE] and 16 unaffected [NL]) agreed to participate in the study and were evaluated at the National Institutes of Health between November 1998 and July 2000. Affected family members were defined as having a level of more than 1.5 × 109 eosinophils/L on 2 occasions at least 6 months apart. Patients with nonfamilial HES (n = 7) or helminth infection and peripheral eosinophilia of more than 1.5 × 109/L (parasitic infections [PARAs]; n = 8) evaluated at the National Institutes of Health during the same time period under separate clinical protocols were included for comparison. None of the HES or parasitic disease patients were receiving treatment for their condition at the time of the study, although 2 of the HES patients had received short courses of steroids in the past. Demographic characteristics of the study participants are given in Table 1. Three of the HES patients have since been shown to have the FIP1L1/PDGFRA (Fip1-like 1/platelet-derived growth factor α) mutation (myeloproliferative HES3 ) and one has a clonal T-cell population (lymphoproliferative HES10 ). The study was approved by the institutional review board of the National Institute of Allergy and Infectious Diseases, and informed consent was obtained from all study participants.
Characteristics of the study population
. | FE, n = 15 . | NL, n = 16 . | HES, n = 7 . | PARA, n = 8 . |
|---|---|---|---|---|
| Median age, y (range) | 39 (1-76) | 39 (1-72) | 40 (16-56) | 31 (16-59) |
| Sex, n, M/F | 9/6 | 7/9 | 6/1 | 4/4 |
| GM eosinophils, × 109/L (range) | 3.314* (2.184-5.292) | 0.252 (0.95-0.520) | 5.607* (1.9-27.492) | 4.639* (1.508-10.496) |
. | FE, n = 15 . | NL, n = 16 . | HES, n = 7 . | PARA, n = 8 . |
|---|---|---|---|---|
| Median age, y (range) | 39 (1-76) | 39 (1-72) | 40 (16-56) | 31 (16-59) |
| Sex, n, M/F | 9/6 | 7/9 | 6/1 | 4/4 |
| GM eosinophils, × 109/L (range) | 3.314* (2.184-5.292) | 0.252 (0.95-0.520) | 5.607* (1.9-27.492) | 4.639* (1.508-10.496) |
GM indicates geometric mean.
No significant difference between groups
Clinical evaluation
All study participants underwent a comprehensive medical history, physical examination, and laboratory testing, including complete blood count with differential; erythrocyte sedimentation rate; serum immunoglobulin G (IgG), IgA, IgM, and IgE levels; urinalysis; and stool tests for ova and parasite. Evaluation of FE, NL, and HES patients also included electrocardiogram (EKG), echocardiogram, pulmonary function tests, and bone survey (FE and NL only). Formal evaluation by cardiology, dermatology, hematology, neurology, and ophthalmology was performed in a standardized fashion in all patients, and consultants (with the exception of hematology) were blinded with respect to the status of FE and NL patients. Additional tests (eg, skin biopsy, chest computed tomography [CT]) were performed if clinically indicated.
FE and NL patients underwent clinical genetic evaluation, including craniofacial anthropometry (CFA). For CFA, 22 variables were selected to represent craniofacial widths, lengths, depths, and circumference, as described by Allanson.11 Measurements were recorded to the nearest 0.5 mm using sliding and spreading blunt-ended calipers and a paper metric tape measure. Population norms for each dimension were derived from measurements in healthy 25-year-old North American white adults.12 The raw data were compared with normal standards and converted to Z scores to control for sex differences. Pattern profiles were derived for affected and unaffected males and females, and a pattern profile variability score (σz) was calculated for each group. An abnormal σz was defined as more than 1.27.13
Electron microscopy
Peripheral blood samples were drawn into a heparinized tube on ice and centrifuged immediately. Freshly spun buffy coats were fixed en bloc in 2.5% gluteraldehyde in 0.1 M phosphate buffer (pH 7.4) on ice for at least 1 hour in the collection tube before removal with a wooden spatula. A full-thickness section was diced into 1 × 1 × 1-mm cubes and fixed in the same solution overnight. Sections were then fixed in 1% osmium tetroxide in 0.1 M phosphate buffer (pH 7.4), rinsed, dehydrated through a series of ethanol solutions, cleared with propylene oxide, and embedded in Epon.
For quantification of piecemeal degranulation and lipid body numbers, 20 photographs containing whole eosinophil cross sections were examined from each patient. All granules in each whole eosinophil cross-section in the electron micrograph were assessed for ultrastructural evidence of degranulation, and a score was assigned based on the number of degraded versus normal appearing granules in the cell as follows: 0 indicates no granules with evidence of degranulation seen; 1, less than 50% of the granules showing degranulation; and 2, at least 50% of the granules showing degranulation. Empty space within the cytoplasm of the cell was not considered evidence of degranulation. The mean degranulation score and mean number of lipid bodies per eosinophil cross section were calculated for each patient.
Eosinophil surface marker expression
Whole blood was stained with directly conjugated antibodies to CD23, CD25, CD40, HLA-DR, CD9, CD69, IgG1, and CD16 (BD Biosciences, San Diego, CA). Irrelevant, directly conjugated, murine IgG1 was used to ascertain background staining. CD9 was used as a positive control for eosinophils. Whole blood cells were incubated with CD16 and the specific surface markers for 30 minutes at 4° C. Red blood cells were lysed using fluorescence-activated cell sorter (FACS) lysing solution (BD Biosciences). Samples were analyzed on a FACScan using CellQuest software (BD Biosciences). Eosinophils were separated from granulocytes by their characteristic high side scatter and dim staining for CD16. Percent positive for each surface molecule was determined by running a fluorescein isothiocyanate (FITC)–conjugated subclass control and setting a marker so that more than 98% of the control was defined as negative.
Serum levels of eosinophil granule proteins
Levels of serum eosinophil-derived neurotoxin (EDN), major basic protein (MBP), and eosinophil cationic protein (ECP) were determined by enzyme-linked immunosorbent assay (ELISA) using standard methods. Briefly, Immulon 4 flat-bottom plates (Thermo LabSystems, Franklin, MA) were coated with monoclonal antibody (6D1.5/A5 anti-EDN, D4 anti-MBP, or 1C8.5/D9 anti-ECP) at 2.5 mg/mL in phosphate-buffered saline (PBS) overnight at 4° C. The plates were blocked for 1 hour with PBS/Tween/0.1% bovine serum albumin (BSA) prior to overnight incubation of sera. Granule proteins were detected by sequential incubation with rabbit polyclonal anti-EDN, anti-MBP, or anti-ECP followed by alkaline phosphatase–labeled goat antirabbit IgGFc and alkaline phosphatase substrate (Sigma, St Louis, MO). All assays were performed in duplicate and values were calculated based on a standard curve. Of note, the anti-MBP antibodies used in this assay do not distinguish between monomer MBP and its precursor proMBP.
Eosinophil purification
Granulocytes were purified from peripheral blood obtained by venipuncture or apheresis by sedimentation over Ficoll-Hypaque (Pharmacia, Uppsala, Sweden). Red blood cells were lysed by hypotonic shock using sterile ice-cold water and cell debris was removed by washing in PBS supplemented with 1% BSA and 0.1 mM EDTA (ethylenediaminetetraacetic acid). Eosinophils were purified using a 2-step negative immunomagnetic selection. First, neutrophils were removed using anti-CD16–coated magnetic beads (Miltenyi Biotech, Auburn, CA). Residual contaminating lymphocytes and monocytes were then removed using a cocktail of anti-CD20–coated, anti-CD3–coated, and anti-CD14–coated magnetic beads (Miltenyi Biotech). Purity and viability of eosinophils was routinely more than 99% as assessed by Diff-Quick (Dade Behring, Newark, DE) staining and enumeration of 100 cells and trypan blue exclusion, respectively.
Eosinophil survival
Purified peripheral blood eosinophils were cultured at a concentration of 0.5 × 106/mL in 200 μL C-RPMI (RPMI [BioWhittaker, Walkersville, MD] supplemented with 20 mM glutamine [BioWhittaker], HEPES [N-2-hydroxyethylpiperazine-N′-2-ethanesulfonic acid], and 50 μg/mL gentamicin [Mediatech, Herndon, VA]) with 10% heat-inactivated human bovine serum (Harlan Bioproducts for Science, Madison, WI) and 10 mM sodium pyruvate (BioWhittaker) in flat-bottom 96-well tissue culture plates (Costar, Cambridge, MA). Recombinant human IL-5 (0-0.5 ng/mL; BD Biosciences) and/or dexamethasone (0-100 mM; Sigma) was added to triplicate wells and plates were incubated at 37° C in 5% CO2. After 4 days, the contents of each well were transferred to 12 × 75-mm polystyrene tubes (Falcon, Becton Dickinson Labware, Lincoln Park, NJ), and 200 μL propidium iodide (PI; final concentration, 0.5 μg/mL) was added to each tube to stain dead cells. Stained cells were analyzed using a FACSCaliber using CellQuest software (BD Biosciences). Eosinophil survival is calculated as relative percent survival (percentage of the control) according to the following equation: relative eosinophil survival = (% survival/% survival at maximum cytokine concentration) × 100.14 Eosinophils cultured with IL-5 (0.5 ng/mL) routinely showed more than 70% survival, whereas less than 10% of cells cultured in control medium were alive at 4 days.
Statistical analysis
Nonparametric comparisons of group means were made using the Mann-Whitney U test. Spearman rank correlation was used to determine the presence of a relationship between nonparametric variables. A P value of less than .5 was considered statistically significant for all tests.
Results
Clinical evaluation
All 31 family members (15 affected and 16 unaffected) underwent a detailed clinical evaluation with particular attention to organs most commonly affected by hypereosinophilic syndrome, including the heart, lungs, peripheral nervous system, and skin (Table 2). No clinical abnormalities were more common in the affected family members compared with the NLs. In the prior study by Lin et al,8 eosinophilia and cardiac abnormalities were described in 5 family members. Two family members with eosinophilia developed fatal endomyocardial fibrosis, one of whom (the proband in the study) also had documented peripheral neuropathy. In the present study, cardiac valvular disease, as defined by structural abnormality seen on echocardiography or mild to severe regurgitation by Doppler, was detected in 3 of 15 affected and 2 of 16 unaffected family members. The 3 family members with eosinophilia and cardiac abnormalities were the same family members identified in the earlier study. During the 10 to 12 intervening years between the 2 studies, cardiac disease had not progressed in 2 family members (one with mild mitral regurgitation and the second with moderate aortic regurgitation). The third family member underwent aortic valve replacement shortly after the prior study for aortic regurgitation with a thickened aortic valve and dilated left ventricle. No evidence of endomyocardial fibrosis was described at the time of valve replacement and he has remained stable without treatment directed at reducing his eosinophil count. Slides and tissue blocks were no longer available for study at the time of the present study.
Clinical findings in patients with family members with FE compared with those in unaffected family members
Organ system and clinical manifestations . | Affected, n = 15 . | Unaffected, n = 16 . | P . |
|---|---|---|---|
| Cardiac | NS† | ||
| Valvular disease* | 3 | 2 | |
| AV block | 3 | 1 | NS |
| Neurologic | |||
| Peripheral neuropathy | 3 | 2 | NS |
| TIA/cognitive decline | 2 | 0 | NS |
| Migraine | 2 | 0 | NS |
| Tremor | 2 | 2 | NS |
| Pulmonary | |||
| Obstructive disease | 1 | 7 | < .001 |
| Skin | |||
| Psoriasis | 1 | 2 | NS |
| Psychiatric | |||
| Depression | 2 | 2 | NS |
| Ophthalmologic | |||
| Cortical cataracts | 6 | 2 | NS |
| Cortical vacuoles | 4 | 4 | NS |
| Nuclear cataracts | 1 | 2 | NS |
| Prior cataract surgery | 1 | 2 | NS |
| Any abnormality | 12 | 10 | NS |
Organ system and clinical manifestations . | Affected, n = 15 . | Unaffected, n = 16 . | P . |
|---|---|---|---|
| Cardiac | NS† | ||
| Valvular disease* | 3 | 2 | |
| AV block | 3 | 1 | NS |
| Neurologic | |||
| Peripheral neuropathy | 3 | 2 | NS |
| TIA/cognitive decline | 2 | 0 | NS |
| Migraine | 2 | 0 | NS |
| Tremor | 2 | 2 | NS |
| Pulmonary | |||
| Obstructive disease | 1 | 7 | < .001 |
| Skin | |||
| Psoriasis | 1 | 2 | NS |
| Psychiatric | |||
| Depression | 2 | 2 | NS |
| Ophthalmologic | |||
| Cortical cataracts | 6 | 2 | NS |
| Cortical vacuoles | 4 | 4 | NS |
| Nuclear cataracts | 1 | 2 | NS |
| Prior cataract surgery | 1 | 2 | NS |
| Any abnormality | 12 | 10 | NS |
NS indicates not significant; AV, atrioventricular; and TIA, transient ischemic attack.
Defined as any structural abnormality of a valve seen on echocardiography or mild to severe regurgitant flow as assessed by Doppler
P > .1
Pulmonary function tests, including measurement of diffusion capacity, did not detect evidence of restrictive disease in any of the 31 study participants. Interestingly, obstructive pulmonary disease, as defined by a history of asthma and/or a decreased FEV1/FVC (forced expiratory volume 1/forced vital capacity) ratio, was significantly more common in the unaffected family members (7 of 16 vs 1 of 15; P < .001). There was no difference between affected and unaffected family members with respect to smoking history or atopic skin disease.
Based on systematic detailed clinical genetic evaluation, including craniofacial anthropometry, no significant dysmorphology was demonstrated in the FE cohort. Although some minor pattern variability was noted (maximum σz = 0.5), comparison between groups suggested that this was due to familial, rather than disease-related, patterning (data not shown).
Eosinophil morphology
Eosinophil morphology was examined by both light and electron microscopy. Peripheral blood eosinophils from family members with FE showed normal morphology and were indistinguishable from those of unaffected family members, as assessed by light microscopy of modified Wright staining of peripheral blood smears (Figure 1A-B). In contrast, eosinophils in peripheral blood smears from the patients with HES showed areas of cytoplasmic clearing, a feature that has been described previously in this disorder15 (Figure 1C). Myelocytes and promyelocytes, which were present in the peripheral blood smears of 3 of 7 patients with HES, were not seen in any of the affected or unaffected family members.
Peripheral blood smears. Representative peripheral blood eosinophils from a patient with FE (A), an NL family member (B), and a patient with HES (C) stained with modified Wright stain (original magnification, × 1000). There is evidence of dysplasia with areas of cytoplasmic clearing only in the eosinophils from the patient with HES.
Peripheral blood smears. Representative peripheral blood eosinophils from a patient with FE (A), an NL family member (B), and a patient with HES (C) stained with modified Wright stain (original magnification, × 1000). There is evidence of dysplasia with areas of cytoplasmic clearing only in the eosinophils from the patient with HES.
Ultrastructural changes characteristic of eosinophil activation include piecemeal degranulation and increases in the numbers of lipid bodies16 (Figure 2). Electron microscopy was performed on peripheral blood eosinophils from 9 affected and 7 unaffected family members. There was no significant difference in the extent of piecemeal degranulation (mean degranulation score of 0.4 vs 0.5) or the numbers of lipid bodies (mean number of lipid bodies/cell of 0.67 vs 0.68) in eosinophils between affected and unaffected family members. A significant increase in mean lipid body numbers was seen in HES eosinophils compared with affected family members (1.76 vs 0.67; P = .04).
Electron micrographs of representative eosinophils from 2 patients with FE. Only one FE patient had any evidence of altered eosinophil morphology, consisting of piecemeal degranulation (arrow) in approximately 20% of his eosinophils (B). White arrows indicate lipid bodies. Original magnification, × 5000.
Electron micrographs of representative eosinophils from 2 patients with FE. Only one FE patient had any evidence of altered eosinophil morphology, consisting of piecemeal degranulation (arrow) in approximately 20% of his eosinophils (B). White arrows indicate lipid bodies. Original magnification, × 5000.
Eosinophil surface phenotype
Cell surface markers reported to be up-regulated on activated eosinophils include CD69, CD25, and HLA-DR.17,18 Whereas the percentage of eosinophils expressing CD69, CD25, and HLA-DR were all found to be increased in family members with FE (2.88%, 0.66%, and 6.37%, respectively) compared with unaffected family members (0.69%, 0.12%, and 2.96%; Table 3), the percentage of CD25+ cells in family members with FE (0.66%) was significantly decreased compared with patients with HES (4.34%; P < .01). No significant differences were found in the expression of eosinophil surface markers between patients with FE or PARA.
Expression of surface activation markers (CD23, CD25, CD69, and HLA-DR) on eosinophils from unaffected family members (NLs) and patients with FE, HES, or parasitic infections (PARAs)
Patient group . | GM % CD23 (range) . | GM % CD25 (range) . | GM % CD40 (range) . | GM % CD69 (range) . | GM % HLA-DR (range) . |
|---|---|---|---|---|---|
| HES, n = 7 | 1.28 (0.4-1.8) | 4.34 (1.1-22.5) | 0.66 (0.4-1.2) | 5.64 (1.3-18.5) | 3.91 (1.9-33.7) |
| FE, n = 14 | 1.87 (0.6-9.8) | 0.66* (0.2-1.2) | 0.72 (0.3-1.3) | 2.88† (0.3-9.1) | 6.37‡ (1.3-38.2) |
| NL, n = 14 | 2.52 (0.3-10.3) | 0.12 (0.001-1.1) | 0.43 (0.001-2.5) | 0.69 (0.3-1.7) | 2.96 (0.9-15.8) |
| PARA, n = 9 | 1.15 (0.3-5.2) | 0.62 (0.001-6) | 0.48 (0.1-0.9) | 3.02 (0.2-13.6) | 6.05 (1.1-41.6) |
Patient group . | GM % CD23 (range) . | GM % CD25 (range) . | GM % CD40 (range) . | GM % CD69 (range) . | GM % HLA-DR (range) . |
|---|---|---|---|---|---|
| HES, n = 7 | 1.28 (0.4-1.8) | 4.34 (1.1-22.5) | 0.66 (0.4-1.2) | 5.64 (1.3-18.5) | 3.91 (1.9-33.7) |
| FE, n = 14 | 1.87 (0.6-9.8) | 0.66* (0.2-1.2) | 0.72 (0.3-1.3) | 2.88† (0.3-9.1) | 6.37‡ (1.3-38.2) |
| NL, n = 14 | 2.52 (0.3-10.3) | 0.12 (0.001-1.1) | 0.43 (0.001-2.5) | 0.69 (0.3-1.7) | 2.96 (0.9-15.8) |
| PARA, n = 9 | 1.15 (0.3-5.2) | 0.62 (0.001-6) | 0.48 (0.1-0.9) | 3.02 (0.2-13.6) | 6.05 (1.1-41.6) |
P < .01 FE compared with NL or HES, Mann-Whitney U test
P = .02 FE compared with NL, Mann-Whitney U test
P < .01 FE compared with NL, Mann-Whitney U test
Serum levels of eosinophil granule proteins
Serum levels of the eosinophil granule proteins, ECP, EDN, and MBP, are elevated in a number of conditions associated with eosinophilia and are thought to reflect the state of activation of circulating eosinophils.19 Although serum levels of EDN and MBP were significantly elevated in patients with FE (geometric mean [GM] 162 and 379 ng/mL, respectively) compared with unaffected family members (GM 35 and 273 ng/mL; P < .01), serum levels of both granule proteins were lower than in patients with HES (GM 7820 and 510 ng/mL; P < .05; Figure 3). Serum levels of EDN and MBP were correlated with the absolute eosinophil count when data from all of the patients studied were analyzed together (P < .0005; Spearman rank correlation) but not if unaffected family members were excluded (Figure 4; P = .66). Geometric mean serum ECP levels were comparable in all of the groups tested.
Serum levels of EDN, MBP, and ECP in unaffected family members (NLs) and patients with FE, HES, or parasitic infections (PARAs). Each symbol represents the serum level for an individual patient. The shaded boxes show the geometric mean level for the entire group. *P < .01 versus FE; **P < .05 versus FE.
Serum levels of EDN, MBP, and ECP in unaffected family members (NLs) and patients with FE, HES, or parasitic infections (PARAs). Each symbol represents the serum level for an individual patient. The shaded boxes show the geometric mean level for the entire group. *P < .01 versus FE; **P < .05 versus FE.
Lack of relationship between absolute eosinophil count and serum EDN level in patients with eosinophilia.
Lack of relationship between absolute eosinophil count and serum EDN level in patients with eosinophilia.
Eosinophil survival
Since prolongation of eosinophil survival in vitro has been described in patients with HES and appears to correlate with a hypodense (activated) phenotype,20 we assessed eosinophil survival after 4 days of culture with and without exogenous IL-5 in 4 patients with FE and 2 unaffected family members. Eosinophil survival in media was less than 10% at 4 days in all 4 patients with FE and increased in a dose-dependent fashion with the addition of IL-5. This increased in vitro survival in response to IL-5 was abrogated by the addition of dexamethasone (data not shown). Furthermore, eosinophil survival in media and in response to IL-5 with and without dexamethasone was comparable in patients with FE and unaffected family members.
Discussion
“Benign hypereosinophilia” is a phrase that has been used to describe sporadic patients with unexplained eosinophilia of more than 1.5 × 109/L and no evidence of end organ damage. Although the kindred described in this study was initially identified because of endomyocardial fibrosis and peripheral neuropathy in a family member with eosinophilia,8 most affected family members are completely asymptomatic despite eosinophil counts ranging from 2.184 to 5.292 × 109/L. Furthermore, extensive clinical evaluation reveals no evidence of eosinophil-mediated end organ damage in any of the 15 family members with FE who participated in the present study. The decreased prevalence of obstructive lung disease in eosinophilic family members is intriguing, particularly in view of epidemiologic data suggesting that the prevalence of asthma is decreased in regions of the world where helminth infection (and eosinophilia) is common.21
The eosinophilia in FE appears to begin at birth, as eosinophil counts obtained within 6 months of birth from 3 children born to affected mothers demonstrated eosinophil counts of more than 2 × 109/L in 2 of the 3. The third child is presumably unaffected. Both family members who developed fatal endomyocardial fibrosis were older than 50 years of age at the time of diagnosis, suggesting that the duration of eosinophilia may be a factor in the development of end organ damage. Of the affected family members described in the present study, 6 are older than 50 years of age, including the 3 with cardiac abnormalities. However, detailed evaluation at the time of the present study revealed no evidence of progression of cardiac disease despite the fact that none of the patients had received treatment directed at lowering their eosinophil counts. Furthermore, longitudinal data, including eosinophil counts obtained over a 20- to 30-year period in some family members, show remarkable stability in the absolute eosinophil count over time, and neither absolute eosinophil counts nor serum levels of eosinophil granule proteins are correlated with age among affected family members (data not shown). Thus, although we cannot exclude a role for duration of eosinophilia in the development of end organ involvement, it seems most likely that a second event is responsible for disease progression.
Degranulation of activated eosinophils in the tissues is thought to play a major role in the pathogenesis of eosinophil-related disorders, and deposition of granule proteins can be demonstrated in affected tissues of patients with HES.7 Serum levels of eosinophil granule proteins provide an indirect measure of degranulation and are elevated in patients with a variety of disorders associated with eosinophilia, including helminth infection, atopic diseases, and HES.19,22 Although morphologic changes associated with degranulation were not seen in peripheral blood eosinophils from patients with FE at either the light microscopic or ultrastructural levels, serum levels of EDN and MBP were significantly increased in comparison to levels in the serum of unaffected family members. Serum levels of these 2 granule proteins were, however, significantly lower than those seen in patients with HES despite comparable peripheral eosinophilia, consistent with a lesser degree of eosinophil activation in patients with FE. Interestingly, the patients with eosinophilia due to parasitic infection had comparable serum levels of eosinophil granule proteins to the family members with FE, despite significant eosinophil-related pathology in 3 patients (pulmonary infiltrates and fibrosis in a patient with tropical pulmonary eosinophilia and severe skin manifestations in 2 patients, one with loiasis and one with localized onchodermatitis or sowda).
Up-regulation of a number of surface molecules, including CD69, CD25, CD44, and HLA-DR, has been reported on activated peripheral blood eosinophils in vivo in patients with helminth infection23 and asthma24 and in vitro in response to activation with IL-5, IL-3, or GM-CSF.23,25 Furthermore, it has been suggested that the pattern of up-regulation of these molecules may reflect not only the degree of activation but also the nature of the activating stimulus.25,26 Consistent with the results of the serum granule protein measurements, eosinophils from patients with FE demonstrated an intermediate phenotype with increased surface expression of CD69, CD25, and HLA-DR compared with eosinophils from unaffected family members but decreased expression of CD25 (and possibly CD69) compared with eosinophils from patients with HES. CD40 and CD23 levels were not different between any of the patient groups studied.
The etiology of the eosinophil activation seen in patients with FE remains uncertain. Neither morphologic examination nor studies of eosinophil survival provided evidence of an intrinsic abnormality in the eosinophils of patients with FE compared with healthy family members. In studies not shown, differentiation of CD34+ peripheral stem cells from affected and unaffected family members in the presence of G-CSF showed normal skewing toward the neutrophil lineage, inconsistent with a primary abnormality in eosinophilic precursor cells (A.D.K. and H.E. Rosenberg, unpublished results, July 2000). Finally, prior studies have not demonstrated elevated serum levels of eosinophilopoietic cytokines8 or mutations in the coding or promoter regions of eosinophilopoietic cytokines, including IL-3, IL-5, and GM-CSF.9
In conclusion, despite prolonged marked eosinophilia, FE can be distinguished from HES by a more benign clinical course and a relative lack of eosinophil activation. These findings suggest that the underlying genetic defect in FE is responsible for an increase in peripheral blood eosinophil levels but does not necessarily lead to eosinophil activation and tissue damage. The factors leading to disease progression in a small subset of patients with FE are unknown, as none of the patients in the current study had definitive evidence of eosinophil-related end organ damage. Long-term follow-up of patients with FE, as well as the specific identification of the etiologic genetic abnormality, will be essential to our further understanding of the pathogenesis of this disorder and of eosinophilia in general.
Prepublished online as Blood First Edition Paper, February 26, 2004; DOI 10.1182/blood-2003-11-3850.
The publication costs of this article were defrayed in part by page charge payment. Therefore, and solely to indicate this fact, this article is hereby marked “advertisement” in accordance with 18 U.S.C. section 1734.
The authors would like to acknowledge Laura Fontaine for assistance in recontacting the family members described in this study, the late Dr Ferrans for his guidance in setting up the electron microscopy studies, Ann Dvorak for review of the electron micrographs, and Emily Carrier for help with the eosinophil survival assays. The authors would also like to thank all of the family members who participated in the study for their time and cooperation without which this study would not have been possible.

This feature is available to Subscribers Only
Sign In or Create an Account Close Modal